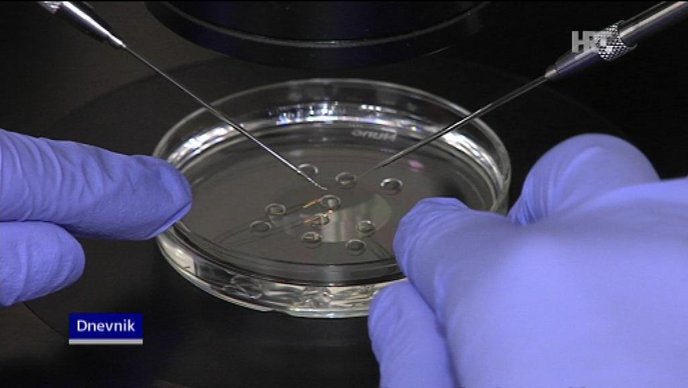

Hrvatska
Stvoren prvi umjetni ’embrij’ miša iz matičnih stanica
Znanstvenici u Velikoj Britaniji uspjeli su stvoriti strukturu nalik embriju miša koristeći se 3D modelom i dvama tipovima matičnih stanica. Njihovo bi otkriće trebalo pomoći u razumijevanju najranijih stadija u razvoju sisavaca.
U radu objavljenom u znanstvenom časopisu Science, znanstvenici sa Sveučilišta u Cambridgeu objasnili su da je umjetni embrij vrlo nalik stvarnome, ali nije izgledno da bi se mogao razviti u zdravi fetus miša. Međutim, na svome su otkriću pokazali da umjetni embrij prati model razvoja kao i normalni embrij jer se na jednak način organiziraju matične stanice.
Voditeljica projekta Magdalena Zernicka-Goetz, profesorica na Odjelu za fiziologiju, razvoj i neuroznanost na Cambridgeu, rekla je da bi uspjeh sa stanicama miša trebao utrti put za sličan rad s ljudskim matičnim stanicama. To bi znanstvenicima pomoglo da premoste nedostatak ljudskih embrija, a upravo je to glavna zapreka u istraživanju ljudskog embrija. Za sada se ljudski embriji za istraživanja razvijaju iz viška doniranih jajašaca s klinika za fertilitet. Moguće korištenje matičnih stanica za izradu umjetnih humanih embrija u znanstvene svrhe omogućilo bi nam proučavanje važnih događaja u kritičnoj fazi ljudskog razvoja, a da pritom ne bismo morali raditi na embrijima, kaže Zernicka-Goetz.
Spoznaja o tome kako se normalno razvija embrij omogućila bi nam da razumijemo zašto tako često stvari krenu po zlu, objašnjava.
Prethodni pokušaji razvoja struktura nalik embriju nisu bili uspješni. Ekipa s Cambridgea drži da je razlog tomu što su se pri dosadašnjim eksperimentima stručnjaci koristili jednim tipom matičnih stanica, embrionalim matičnim stanicama, umjesto kombinacijom, a pri ovom su projektu upotrijebljene stanice ESC i ekstraembrionalne trofoblastične matične stanice. I jedne i druge počinju razgovarati i organiziraju se u strukturu koja izgleda i ponaša se kao embrij, kaže Zernicka-Goetz.
Rad kolega s Cambridgea pozdravili su i stručnjaci koji ne sudjeluju u projektu. Dr. Duško Ilić s King’s Collegea u Londonu nazvao je otkriće remekdjelom i prekrasno koncipiranom i izvedenom studijom koja pokazuje međuigru različitih stanica u različitim staničnim odjelima u prvim danima razvoja miša.
Hrvatska
Slovenci uputili neobičan zahtjev zbog brojnih turista koji će ići prema Hrvatskoj

Slovenska državna tvrtka za upravljanje autocestama upozorila je tamošnje Ministarstvo uprave da će s prvosvibanjskim praznicima početi gužve na slovenskim cestama. Predlaže da zaposlenici u javnoj upravi najprometnije dane rade od kuće.
DARS, slovenska državna tvrtka za upravljanje autocestama, u dopisu je predložila tamošnjem Ministarstvu uprave da zaposlenici u javnoj upravi najprometnije dane u svibnju rade od kuće.
Na taj način pokušali bi rasteretiti promet tijekom najkritičnijih dana kad je riječ o gužvama na cestama. Prvi je to takav DARS-ov apel.
DARS je upozorio Ministarstvo da će s prvosvibanjskim praznicima početi gužve na slovenskim cestama. Navode da će se dnevnim putnicima do radnih mjesta pridružiti i turisti, a upravo je to razlog apela.
Istaknuli su da je prometno najkritičnije područje Ljubljane. Na temelju dosadašnjih iskustava, uvjereni su da bi rad od kuće u javnoj upravi doprinio boljoj protočnosti prometa u glavnom gradu.
Ministarstvo je dobilo niz datuma kada će stanje na cestama biti najgore. Slovenski N1 navodi da prema neslužbenim informacijama Ministarstvo ne planira poslušati DARS te da bi takvu odluku trebala donijeti Vlada.
“Tijekom prvosvibanjskih praznika očekujemo pojačan promet iz unutrašnjosti Slovenije prema turističkim središtima u slovenskoj Istri kao i dalje prema Hrvatskoj. Isti, ali u suprotnom smjeru, pojačan promet, uključujući i gužve, možemo očekivati na kraju prvosvibanjskih praznika prema unutrašnjosti Slovenije”, kažu u PU Koper.
Prema iskustvu, već sada se mogu očekivati gužve na autocesti, posebice na područjima gdje se izvode građevinski radovi.
Dakako, gužve se mogu očekivati i na područjima gdje su redovite gužve zbog prometne infrastrukture, odnosno na dionici između Izole i Lucije, na Šmarskoj cesti te ispred bivših graničnih prijelaza s Hrvatskom, dodaju.
Odmah nakon praznika rada na ljubljanskoj obilaznici doći će do velikih prometnih gužvi zbog vjerskih blagdana, slobodnih dana i godišnjih odmora u Austriji, Njemačkoj, Švicarskoj, Belgiji, Nizozemskoj i Hrvatskoj.
Stoga očekuje se kako će se velik broj turista iz zapadne Europe uputiti u Hrvatsku.
Hrvatska
Ovo je zemlja u koju bi Hrvati najradije selili. Analitičar: “To ne čudi. Više je razloga”

Otkako je 2013. godine primljena u Europsku uniju, iz Hrvatske je iselilo više od 400 tisuća ljudi. Velika većina njih iselila je iz ekonomskih razloga, zbog kvalitentijih i bolje plaćenih poslova te uvjeta rada.
Uz Njemačku i Austriju, zemlje u koje su Hrvati najviše iseljavali i prije ulaska u EU i na europsko tržište rada, privlačnom zemljom za život i rad postala je i Irska.
Trend iseljavanja iz Hrvatske vjerojatno neće jenjavati još neko vrijeme. U međuvremenu je otpočeo i trend useljavanja u Hrvatsku s masovnijim dolaskom ekonomskih migranata iz azijskih zemalja poput Indije, Nepala, Bangladeša, Filipina… Godina 2022. bila je prva u kojoj je zabilježen pozitivan migracijski saldo jer je u Hrvatsku uselilo više ljudi, nego što je iselilo.
Hrvati bi najradije u Austriju
Američki poslovni portal Remitly svojedobno je objavio kartu najpopularnijih zemalja za Europljane koji žele seliti u inozemstvo, a na temelju Googleovih podataka o najčešće unošenim pojmovima prilikom pretraživanja vezanih uz posao i preseljenje.
Prema tim podacima, Hrvati ne bi išli daleko trbuhom za kruhom – najradije bi u Austriju. Austrija je najpoželjnija i Slovencima. Za Bosnu i Hercegovinu, Srbiju i Sjevernu Makedoniju nema podataka.

“Tamo možemo i u dnevne migracije”
Komentirajući nam taj podatak, ekonomski analitičar Damir Novotny kaže da pri tom odabiru važnu ulogu igra geografski faktor.
“Austrija, posebno Beč, ali i drugi gradovi, tradicionalno su proglašavani najboljim mjestima za život. U gradovima poput Beča, Salzburga, Klagenfurta i Graza nudi se puno radnih mjesta, a blizu su nam. Austrija omogućava i dnevne migracije jer iz sjevernih dijelova Hrvatske do Austrije treba tek sat-dva vožnje. Osim toga, Austrija je u smislu konkurentnosti i kvalitete života jedna od vodećih zemalja u svijetu, en samo u Europi. Privlačnost Austrije Hrvatima ima, osim geografskih i ekonomskih i svoje kulturološke i povijesne razloge”, smatra Novotny.
Njemačka najpopularnija, sjevernjaci bi na jug
Inače, Njemačka je očekivano najpopularnija zemlja za preseljenje, kao što je i očekivano da je njena popularnost najveća u zemljama istočne Europe i Balkana – Poljskoj, Češkoj, Rumunjskoj, Bugarskoj, Grčkoj, Albaniji i Turskoj. Doduše, Njemačka je prvi izbor i Švicarcima koji bi, ako baš moraju sići stepenicu niže sa svog životnog standarda, odabrali zemlju koja im je po tome najsličnija. Također, Nijemcima, Austrijancima i Talijanima prvi izbor je Švicarska.
Francuzima, Belgijancima, Ircima i Britancima prvi izbor za preseljenje je bogata prekomorska Kanada. S druge strane, stanovnicima bogatih zemalja hladnog sjevera – Nizozemske, Švedske i Finske prvi izbor je na toplom jugu – Španjolska.
“Kod njih je standard visok pa je njihov izbor uvjetovan klimatskim razlozima”, napominje Novotny.
Velika Britanija nije omiljeno mjesto
Zanimljivo je da niti u jednoj europskoj zemlji prvi izbor za preseljenje nije Ujedinjeno Kraljevstvo, iako ono tradicionalno “usisava” mnogo useljenika. Razlog tomu Novotny dijelom vidi u britanskim posebnostima poput vožnje lijevom stranom i drugačijeg stila života, ali i u klimi koja mnogima ne odgovara.
“Troškovi života vrlo su visoki i čitav je niz razloga zašto Velika Britanija nije baš omiljeno mjesto za život. Mislim da je brexit tek manjim dijelom razlog tomu”, kazao je Novotny.
Hrvatska
KLIMATSKE PROMJENE / Temperatura u Hrvatskoj toliko će porasti da ćemo “gubiti” 22 dana godišnje

S obzirom na to da za većinu ljudi nije lako dešifrirati utjecaj porasta temperature na njihov svakodnevni život, a teško je zamisliti globalno zagrijavanje od prosječno 1,5 ili 2 stupnja, stručnjaci s američkog MIT-a osmislili su inovativan novi način mjerenja ove promjene u stvarnom životu i predviđanja njezinih dugoročnih učinaka.
Koristeći podatke iz 50 različitih klimatskih modela, stručnjaci s Massachusetts Institute of Technology (MIT) zacrtali su kako će broj “dana na otvorenom” u raznim destinacijama diljem svijeta rasti ili padati do 2100. Ovi ‘dani na otvorenom’ odnose se na razdoblja od 24 sata kada su temperature dovoljno ugodne za većinu ljudi da se bave aktivnostima na otvorenom, bilo zbog posla ili u slobodno vrijeme, prenosi Euronews. To su dani kada nije ni prevruće ni prehladno, što znanstvenici smatraju otprilike između 10 i 25 stupnjeva Celzija, te da u njima ekstremnih vremenskih nepogoda, piše tportal.
Internetski alat koji su razvili istraživači s MIT-a također omogućuje ljudima da postave vlastiti raspon temperature kada provjeravaju podatke iz svoje zemlje na temelju onoga što misle da je ugodno vrijeme. Studija MIT-a pokazala je da će tropska odredišta doživjeti najveće promjene u danima na otvorenom. Najveći udar pretrpjet će Dominikanska Republika koja će do kraja stoljeća izgubiti 124 dana ugodnog vremena godišnje. Meksiko, Indija, Tajland i Egipat izgubit će polovicu dana na otvorenom. Istraživači također ističu podjelu između globalnog sjevera, koji će dobiti više dana ugodnog vremena, i globalnog juga, koji će izgubiti više unatoč tome što je emitirao manje stakleničkih plinova. Razlike u mjestima poput Bangladeša ili Sudana su zapanjujuće, kažu.
U Europi također postoji podjela sjever-jug kada su u pitanju dani na otvorenom. Na sjeveru će biti više dana s ugodnim vremenom jer su zime tople, na jugu će ekstremne vrućine tijekom ljetnih mjeseci uzrokovati pad broja dana na otvorenom. Prema podacima MIT-a, Balkan će vjerojatno biti jedna od najteže pogođenih regija u Europi. Albanija će izgubiti 30 dana, Srbija 26 dana, Hrvatska 22 dana, Sjeverna Makedonija 21 dan, Bugarska 17 dana, Kosovo 19 dana, a Rumunjska 12 dana. Malo južnije, Grčka bi do 2100. mogla izgubiti 37 dana na otvorenom godišnje zbog ekstremnih vrućina između svibnja i rujna, kaže studija MIT-a.
Pirenejski poluotok također će doživjeti promjene, pa će tako Portugal imati 33 dana manje na otvorenom, a Španjolska 13. Istraživači kažu da se razlika u Europi već osjeća i da ljudi biraju kamo će putovati na temelju sve ekstremnijih vrućina na prethodno popularnim odredištima. Iako će zemlje u sjevernoj Europi vjerojatno dobiti više dana na otvorenom zbog klimatskih promjena, ni to nisu sve dobre vijesti. Francuska, Njemačka i Austrija dobit će između 18 i 52 dana ugodnog vremena do 2100. – uglavnom zbog toplijih zima. Ovo bi mogao biti fatalan udarac za europsku skijašku industriju koja je već neko vrijeme u problemima.
-

 magazin13 sati prije
magazin13 sati prijeFOTOGALERIJA / Sunčana subotnja špica u Zadru
-

 magazin2 dana prije
magazin2 dana prijeHoroskop za 26. travnja 2024.
-

 Sport2 dana prije
Sport2 dana prijeSVETI JOSIP RADNIK / MNK Plovanija najavljuje turnir “4 strane Plovanije za Jednog Heroja Ulice”
-

 magazin2 dana prije
magazin2 dana prijeLjudi koji žive 100 godina jedu ovih 10 namirnica




















